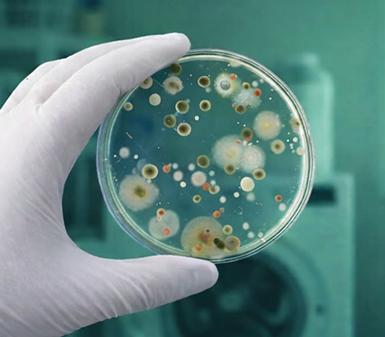

A Hidden Ecosystem Inside Modern Washers Is Releasing Odor-Causing Molecules Into Every Load
And a NASA-Inspired Enzyme Method Is Finally Dissolving the Source Instead of Simply Masking It

Millions of people across Australia are making the same complaint:
Their laundry is coming out of the washer with a sour scent.
Towels that should smell clean develop an odd stale odor.
Blankets seem fine at first, but carry a faint funk that lingers.
Even shirts that look freshly washed begin to smell musty halfway through the day.

For families who take pride in a clean home, it has been embarrassing and somewhat confusing...
Because Laundry is supposed to smell fresh.
And no matter how many times people rewash their clothes, the problem keeps returning.
For decades, everyone pointed fingers at the usual suspects.
Some blamed hard water...

Others blamed humidity...

And many assumed their detergent had stopped working.

But behind the scenes, researchers were uncovering something far bigger.
They found that the odor was not coming from the clothing at all.
But from inside the machine itself, in a way most people have never been told about.

After reviewing university research, government sanitation reports, microbiology papers, and archived NASA data, one conclusion stood out:

Modern washing machines are developing their own internal ecosystems.
They survive every wash cycle.
They feed on residue left behind by detergent.
They attach themselves to clothing almost every time a load goes through.
NASA engineers discovered the same pattern decades ago inside the closed water systems used in space missions.
In those sealed systems, warm water, constant moisture, and zero airflow created the perfect environment for microscopic communities to grow and strengthen.
They clung to surfaces, formed stubborn layers, and released compounds into the air.
Inside the International Space Station, this buildup became so persistent that it threatened vital equipment.

And traditional cleaning methods weren't able to reach the sealed sections where the buildup lived.
While NASA was still testing solutions at the time, their early findings revealed a pattern that now explains exactly what is happening inside modern washers.

Because if your laundry has developed a sour scent...
If your clothes carry a trace of your dog's smell...
Or if you get a whiff of something unpleasant the moment you open the washer...
You are likely dealing with the same hidden environment researchers have been studying for years.
Appliance experts classify this as a contamination issue, not a cleaning one.

But before we get to NASA's breakthrough that changed everything, you need to see what is actually happening inside the machine sitting in your laundry room.
Because once you understand how this hidden environment forms, the smell finally makes sense.
And you realize why your washer cannot clean itself.
For generations, people assumed a washing machine was self-cleaning.

Add detergent.
Run a cycle.
And let it rinse itself out.
But the machines in Australian homes today are not the machines from 20 years ago.
Modern washers use far less water after the U.S. Environmental Protection Agency and the Department of Energy updated national efficiency requirements in the early 2000s.

To meet those rules, manufacturers began designing tightly sealed doors that keep moisture inside long after the cycle ends.
Which means moisture sits inside long after the cycle ends, and water is often recycled during rinsing rather than flushed out completely.
Over time, it creates a closed environment that acts less like a cleaning appliance… and more like a living ecosystem.
So every load contributes something new.
Residual detergent sticks to the inner walls.
Loose threads drift into corners where water doesn't flow.
And piece by piece, this becomes a stable ecosystem.

This ecosystem releases microscopic compounds into every load you wash.
Which is why the smell is so stubborn.
And until that environment is broken down, the smell always returns - no matter how many times you rewash the load.
This leads to the question almost every homeowner eventually asks:
If the problem is inside the machine, why doesn't cleaning the machine fix it?

The answer is simple:
Because most of the "fixes" we were taught only clean the surface, things like:
Running an extra hot cycle
Adding more detergent
Pouring vinegar into the drum
Sprinkling baking soda
Activating the "self-cleaning" setting
Scrubbing the rubber seal by hand
And all of it feels helpful, because it does make the washer look clean.

But none of it reaches the hidden sections where the real problem lives.
Behind the drum is an entirely different environment - one most homeowners never see.
One where moisture lingers in enclosed compartments long after the cycle ends, creating areas that never fully dry.
Where a slow layer of residue forms along the outer tub walls, where water barely moves.

And none of this responds to the usual at-home remedies.
But it wasn't until researchers compared modern washers to other systems with similar conditions that the pattern became impossible to ignore.
In both environments, recycled water moves through the same channels again and again.
Moisture lingers in enclosed pockets that never fully dry.
And residue begins forming layers in the places heat and fresh water rarely reach.
NASA documented the same behavior decades earlier inside space-mission water systems.

The residue inside those sealed systems didn't behave like normal grime.
It formed stubborn layers.
It bonded with fibers, oils, proteins, and minerals.
And over time, it created a shield that blocked heat, water, and chemical cleaners.
NASA eventually realized it wasn't dealing with a surface problem.
It was dealing with a structural one.
So their engineers abandoned traditional cleaning and created a targeted
multi-enzyme method designed to break the residue apart from within.


Advanced Multi-Enzyme Technology
- 1
One enzyme softened protein layers.
- 2
Another broke down oily deposits.
- 3
A third targeted the microscopic fibers holding the structure together.
- 4
Once those layers weakened, oxygen could finally reach deeper sections and lift material that had been sealed off for years.
Piece by piece, the environment collapsed.
This breakthrough is what led researchers to understand why the same approach works inside modern washers.
Modern machines were behaving like small closed systems, not open appliances.
And just like NASA discovered...
No amount of heat, vinegar, baking soda, or "self-clean" cycles can reach the sealed pockets where the real buildup lives
That realization pushed the research toward the same multi-enzyme strategy NASA created when traditional cleaning failed.
The only remaining question was whether anyone could adapt that method for the machines sitting inside homes.

That realization pushed the research toward the same multi-enzyme strategy NASA created when traditional cleaning failed.
The only remaining question was whether anyone could adapt that method for the machines sitting inside homes.
An Australian-based brand saw it early, and started adapting NASA's multi-enzyme method long before the public ever heard about this problem.
And their results quickly became the most talked-about approach in home-care forums for resolving the laundry odor issues homeowners had been unable to solve with any other method
They created a cleaning tablet formulated to reach the sections homeowners physically cannot access.

And it has been spreading quickly through pet-owning homes for one reason:
It removes the smell completely, while every traditional method only masks the smell.
The tablet uses the same three-part mechanism NASA used to break down buildup in sealed systems.
Here is how it works:
Inside each tablet is a blend of enzymes that begin softening the buildup forming behind the drum.

Once the structure weakens, the tablet releases oxygen that lifts loosened material from hidden surfaces.

A surfactant pushes the formula into the narrow compartments where water normally never reaches.

A chelating agent binds to minerals that help anchor the buildup.

And sodium silicate protects the metal surfaces of the washer while the process works.
It cleans the parts of your washer you never see.
The parts where the smell actually starts.

Pet owners notice the biggest change because pet hair breaks into oils and microscopic fibers - the exact mix NASA's enzyme method was built to break apart.
It works because it was designed for the most difficult closed water system ever engineered.


The same type astronauts depend on
And now, for the first time, it is being used for the machines sitting inside homes.
If you have ever wondered why your laundry smells clean for a moment and then slides back into the same odor...
Researchers believe this may finally be a solution that reaches the real source.
That solution is now being used by a growing number of families under a name you may have seen spreading online:
Adoria Washing Machine Cleaner.

It was created by a small Australian-based company that had spent years helping pet owners remove hair from carpets, upholstery, vehicles, and clothing.
But as customer complaints shifted toward lingering laundry odor, the company followed the research.
They saw the same pattern NASA had documented.
They saw the same conditions inside modern high-efficiency machines.
And they realized no household cleaner had been built to reach the places where the problem actually begins.
So they adapted the multi-enzyme strategy used in closed water systems and shaped it into a simple tablet that families could use at home.
After months of testing it among pet owners and homeowners dealing with the most stubborn laundry odor cases, word began spreading...

People weren't just seeing improvement.
They were seeing something they had not been able to get from vinegar, baking soda, hot cycles, or "self-clean" settings.
Mold & Mildew

before

after
Pet Hair

before

after
Dirt

before

after
Detergent Residue

before

after
If you want to see whether the NASA-inspired enzyme method works inside your own machine, there's only one place to get it;
Adoria Washing Machine Cleaner is available exclusively through the company's official site.

And RIGHT NOW, they are offering a limited introductory discount for new customers.
The current offer provides up to 50% off, depending on the supply you select:
24-tab box
for smaller households
48-tab box
for families who run several loads a week
72-tab box
for pet owners or anyone who wants their machine protected long-term
Experts recommend keeping your machine on a regular cleaning schedule to stay ahead of the buildup rather than waiting for the smell to return.
Orders are fulfilled from the company's warehouse.
Availability changes frequently, especially when the product circulates through home-care or pet-owner communities.
You can check availability and current pricing through the link below.
Click here to see if Adoria Washing Machine Cleaner is still in stock





















